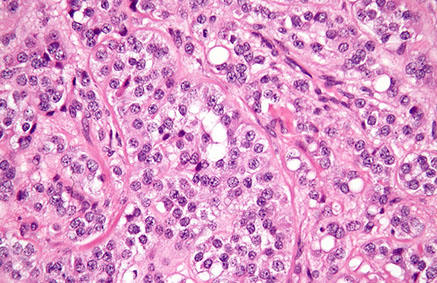

Testis
Paratesticular tissue
Anatomy, Embryology and Histology
Cryptorchidism
Testicular Regression Syndrome (TRS)
Infertility and atrophy
Epididymitis and Orchitis
- Granulomatous orchitis
Germ cell tumors
-
Seminoma
- Spermatocytic seminoma
- Non-Seminomatous Germ Cell Tumors (NSGCT)
-
- Embryonal carcinoma
- Mature (adult) and immature teratoma
- Choriocarcinoma
- Yolk sac (endodermal sinus) tumor
Sex cord-stromal tumors
- (Interstitial) Sertoli cell tumor
- Leydig cell tumor
Testicular Lymphoma
Adenomatoid tumor
Testicular Anatomy
From out to in: skin, dartos muscule (nonstriated, attached to skin), Colle's fascia, external spermatic fascia, parietal layer tunica vaginalis
Overview of sperm journey:
Seminiferous tubules, Epididymis, Vas Deferens, Ejaculatory duct, (Nothing), Urethra, Penis
***SEVEN UP***
Paired reproductive glands that make sperm (spermatogenesis), 2-3C below normal body temp
- covered by tunica vaginalis, a closed off distal part of embryonic processus vaginalis
- tunica albuginea is tough collagen fibrous outer surface which penetrate testis and separate seminiferous tubules into ~250 lobules
Seminiferous tubules go into the straight tubules (tubulus rectus), which go to the rete testis, a network of canals in the testicular mediastinum
- testicular arteries arise from anterior aspect of abdominal aorta beneath renal arteries, crossing over the uereters (*** bridge over water ***) into inguinal rings
- veins form pampiniform venous plexus around spermatic cord which join to form testicular veins (the right testicular vein enters IVC, the left into left renal vein)
Rete testis transports sperm into the efferent ductules, which then go into the epididymis, broken down into head, body and tail (S-->I) where sperm stored and continue to mature
Ductuli efferentes up to 20 spiraling ductules come out of the rete testes
Vas deferens (ductus deferens) continues from the epididymis, and has thick muscular walls and ends by joining the duct of the seminal gland, forming the ejaculatory duct, which (similar to the testicular artery) crosses anterior to the ureter (*bridge over water*)
- lined by pseudostratified columnar epithelium, made of columnars and basal cells by light microscopy
- columnars have short stereocilia and can have lipid vacuoles
- folds are simple in proximal vas and become more convoluted in distal vas
- epithelium in the ampulla has lots of lipofuscin
- can have scary monster cells (like seminal vesicle)
Seminal vesicle glands superior to prostate and secrete a thick alkaline fluid c fructose and a coagulating agenting that mixes with sperm as they go from ejaculatory ducts into the urethra
- don't store sperm (despite name)
- run parallel to vas deferens
- has thin external longitudinal and thick internal circular muscular layer, and can have dispersed hyaline globules
- mucosal folds are simple in kiddos and become complex and alveolar-like in adults c red crystals in lumens
-- mucosal lining is ciliated columnar and cuboidal basal cells, c lipofuscin in cytoplasm
- can sometimes see scary "monster" cells (also seen in vas) in adults
~2.5 cm ejaculatory ducts formed by vas deferens and seminal glands joining
Testicular Embryology
3 phases of growth:
1) static: from birth to 4 years of age
- at birth, seminiferous tubules filled c cuboidal cells and Leydig cells present 2/2 maternal hormones
2) growth: from 4 yo to 10 yo
- growth at 10 yo noticeable c formation of pubertal hormones; start to see mits
3) developmental (maturation) from 10 yo to puberty
- mits prominent at 11 yo, c lots of spermatids present at 12 yo
Each testis 15-19 gms when fully developed, c R testis ~10% heavier than the left
Covered in a 3-layered capsule consisting of outer tunica vaginalis (flat layer of mesothelial cells), tunica albuguinea and inner tunica vasculosa
The growth of a sperm takes ~70 days and follows several steps:
Spermatogonium (types A and B)
Primary spermatocyte (phases: preleptotene, leptotene, zygotene, pachytene, diplotene)
Secondary spermatocyte
Spermatid
(Mature) spermatozoan
Degree of maturation can be graded
An aside, brought to you by the kidney...
3 kidney systems formed during development:
1) Pronephros
- completely obliterated by end of 4th week
2) Mesonephros - produces urine through its excretory tubules from 4th-10th week
Functions for a little while in fetal development
- a few caudal tubules and mesonephric duct persist in males and help in developing genital system, but are completely regresses in females
Mesonephric duct is lateral,
- gonad lateral to mesonephric duct
Paramesonephric duct medial (to mesonephros)
3) Metanephros
- "the permanent kidney"; develops from metanephric mesoderm
Bladder / urethra separate from the genitals
- Cloaca divides from 4th-7th week into urogenital sinus and anal canal (separated by urorectal septum [the taint])
- allantois regresses into the urachus (fibrous strand that connects belly button and bladder [which you can kinda feel if you stick ur finger in your belly button deep enough]) - aka medial umbilical ligament in grownups
Prostate develops from the pelvic (posterio-inferior[?]) part of the urogenital sinus
Primordial germs cells, like magic fairy dust from the epiblast, need to migrate into gonad (at ~5th week) for gonadal development to occur
-- magically transform into primitive sex cords (in both M+F [thus nicknamed indifferent gonad]) after primordial giant cell influence
SRY gene makes "testes determining factor", making the indifferent gonads to differentiate themselves into gonads, specifically the testis
- makes SOX9 and blocks WNT4
Fetal / Prepubertal Testis Histology
Recognizable @7-8 wks gestation by Sertoli cells forming cords, and germ cells (derived from extraembryonic epiblast cells in post wall of yolk sac [adjacent to base of allantois] in 3rd WGA) migrate in to gonadal ridge (transforming them into gonocytes) and can stay pluripotent (few) or make sperm (many)
- gonocytes have round nucleus, prominent nucleolus, and little cytoplasm and seen in central portion of lumenless seminiferous tubules, surrounded by Sertolis
- during last half of gestation and until 6 mo after birth gonocytes undergo mitotic arrest
- then get more cytoplasm and coarse chromatin and nearly all germ cells are spermatogonia by 6th month after birth
Leydig cells appear at 7 WGA; at first are spindly then start to look normal
Sertoli cells are first recognizable cells in testis and help form Leydig cells; mitotically active until first few months after birth
- IHC: (+) PLAP in 1 trimester germ cells, , CD117 in germ cells until end of 1st prenatal year, OCT3 and NANOG in primordial germ cells and gonocytes; inhibin a and vimentin in all Sertoli cells
Gubernaculum (aka caudal ligament of testis) responsible for descent of testis through inguinal canal, looks similar to Whartons jelly
Testicle histology
Organization:
(Central lumen)
Seminiferous epithelium: Somatic or spermatogenic
Somatic cells: Sertoli cells
Spermatogenic cells: spermatogonia, spermatocytes, spermatids
Wall of seminiferous tubule: Fibroblasts and myoid
- contracts rhythmically
Intertubular space: Leydig cells, lymphoid sinuses, arterioles,
Central lumen shows sperm tails and contains fluid
- old person testis has less spermatogenesis, peritubular fibrosis, and seminiferous tubule hyalinization, and rare sclerotic tubules, and Leydig cell # may dec
Seminiferous epithelium
Seminiferous tubules have stratified columnar Sertoli cells (considered somatic cells) extending from BM to lumen (acting as bridge bwt intertubular space and lumen)
- Sertoli cells have irregular plasma membrane which form crypts for developing sperm
- nucleus (found more basally) usually indented c large nucleolus
- may have lipid vacuoles or red granules in cytoplasm (phagocytosed residual bodies)
- represent ~1/10 cells in mature seminiferous epithelium and deplete c age
- form tight junction in basolateral borders, forming blood-testis barrier
- Charcot-Bottcher crystals in basal portion cytoplasm
- have various functions in sperm development, and phagocytose residual bodies(biproduct of speriogenesis (after second meiosis in spermatogenesis)
- stimulated by FSH, which regulates androgen production through androgen-binding protein (ABP) production, which in turn binds testosterone and DHT
- Sertolis secrete inhibin and activin
-- inhibin gives negative feedback inhibition on hypothalamus and pituitary ant hypophysis FSH and GNRH production
-- Activin gives positive feedback on FSH production
- Sertoli cells do not undergo mitosis in the adult testis
- IHC: (+) vimentin, CK8/18 (embryonic Sertolis only), androgen Rs (adults only),
- CYP26B1 breaks down retinoic acid from mesonephric tubules, directing female fetal germs cells away from meiosis
Sertoli cells interact with spermatogenic cells: the spermatogonia, which divide mitotically into spermatocytes and spermatids
- undifferentiated spermatogonia in basal portion c round-oval nuclei c crystalloids of Lubarsh
- secondary spermatocytes have short t1/2 and r few
- sloughing of germ cells may be 2/2 Sertoli cell failure, or artifact
- spermatogonia decrease c age and Sertoli cells become relatively more prominent
- can count sperm in tubules or count Sertoli cell to spermatogonia ratio to see if adequate sperm production (luminal sperm# to seminal fluid sperm count correlates well), should count 20-30 tubules :-\
- IHC: (+) OCT3/4, CD117 (later type A spermatogonia cells)
Leydig cells are found bwt the seminiferous tubules close to nerves, vessels and lymphatics and produce androgens (INSL3) and testosterone
- round vesicular nucleus c 1-2 prominent nucleoli
- Leydig cells have red crystalloids of Reinke , lipofuscin and lipid drops in cytoplasm
- IHC: (+) calretinin, inhibin a, INSL3 (specific), S100, GFAP, SYN, CHR, NSE,
Tubulus rectus connects the seminiferous tubules to the rete testis
The rete testis is a network in testicular mediastinum from tubuli recti to ductuli efferentes
- distal portion of seminiferous tubules usually only made of Sertoli cells that snout out into lumen
- rete is simple squamous to low columnar, c microvilli and lies on a thick BM, and the mediastinal portion can have irregular cavernous channels of intratubular chordae
- can have refractile, PAS+ red globules
Ductuli efferentes connect the rete testes to the epididymis
- looks pseudostratified and have undulating border c ciliated and non-ciliated columnar cells, basal cells and rare intraepithelial lymphos
- has lots of PAS+ red globules and cytoplasmic lipofuscin and surrounded by lots of sm muscle and fibroblasts
- may see occosional Paneth-like cells
Epididymis is a single spiraled duct that forms from the ductuli efferentes and leads to the vas deferens
- broken into head body and tail,
- sperm spend ~12 days here, mostly in caudal portion where they wait to get ejaculated
- have tall columnar cells, basal cells, clear cells, tall apical cells rich in mitochondria c scattered lymphs and macrophages
-- principal cells are 19/20 of all tall columnar cells and form tight junction that regulate luminal exchanges
The vas deferens is a muscular tube that has peristaltic contractions in its smooth muscle wall
- lined by pseudostratified columnar cells and basal cells c stereocilia
- ampullary region has complex infoldings and outpouchings
Seminal vesicles are coiled, paired structures parallel c ampulla of vas deferns, which it joins to form ejaculatory duct
- main duct duplicated in 1/10
- wall has outer longitudinal and inner circular muscle layers
-- red globules seen in muscle portion (possibly degenerating sm muscle cells
- highly complex mucosal folds and alveolar-like in adults
- red stuff and crystals seen in lumen, and may see sperm refluxed in
- can have giant, scary epithelial cells c large, dark, irregular nuclei in epithelium next to normal ciliated columnar cells and basal cells
- lipofuscin prominent in epithelial cells
Ejaculatory ducts arise from seminal vesicle and vas joining, going into prostate and entering posterior prostatic urethra at verumontanum
- surrounded by thin layer of sm muscle, and has epithelium similar to seminal vesicle and ampulla of vas
- may look like prostate ca on bx, lipofuscin in epithelial cells helps to tell that is from ejaculatory ducts; also will be PSA negative (vs prostate cells)
Normal male gonadal function
At puberty, increased secretion of LH and FSH by the pituitary causes development of the testes, causing
spermatogenesis (under the influence of FSH) and production of the major male sex hormone, testosterone (under the influence of LH). Many of
the effects of testosterone are due to peripheral conversion to dihydrotestosterone by the enzyme 5-
a-reductase. If sperm are made, inhibin is produced by Sertoli cells, which decreases FSH secretion; testosterone inhibits LH release


pT0 = no evidence of primary tumor
pTis = Intratubular germ cell neoplasia (carcinoma in situ)




Tunica albuginea


Epididymis


Epididymis

vas deferns

vas deferens
Cryptorchidism
Failure of the testes to descend to the scrotum, usually remaining within the inguinal canal
- in 10% of males at birth; persists in 1% of males at 1 year
- 80% are unilateral
- related (possibly) to testosterone levels
2 phases of testicular descent:
1) Intra-abdominal: controlled by mullerian-inhibiting hormone
2) Inguinoscrotal: testes descend from inguinal canal into scrotum, under control of androgens
- may be controlled by release of calcitonin gene-related peptide from the genitofemoral nerve
Gross: Cryptorchid testes in adults look small and brown
Micro: developmental arrest in germ cell development c hyalinization / thickening of BM and inc in interstitial stroma
- Leydig cells spared and thus appear prominent
Tx: Orchiopexy if not descended by 2-3 yo
Px: Assoc c infertility and inc risk testicular ca (ie germ cell tumor [seminoma]), ~3-14% overall
- inguinal hernia common (10-20%)
- orchiopexy may not improve fertility or cancer risk, even in contralateral testis
Testicular Regression Syndrome (TRS)
- aka vanishing testes syndrome
fibrovascular nodule c assoc hemosiderin-laden macrophages and dystrophic calcification
- residual tubules in 1/10, sometimes seminiferous tubules and viable germ cells
- theoretically has potential for malignant degeneration, though has not been reported
Infertility and atrophy
May be caused by cryptorchidism, vascular disease, cachexia, excessive female hormones (exogenous or endogenous from cirrhosis), radiation / chemo / environmental toxicity, genetic dz (Klinefelter's)
May be divided into pre- / intra- / and post-testicular etiologies
- pre = hormonal
- intra = cryptorchidism
- post = testicular outflow obstruction
Epididymitis and Orchitis
Inflammation is MC in the epididymis than testis
- TB and gonorrhea usually seen first in epididymis; syphilis comes out in testis first
Gonorrhea starts in posterior urethra and goes to prostate, seminal vesicles and finally epididymis
- may cause granuloma formation or suppurative orchitis
Mumps causes orchitis in about 1/3 males who contract the dz post-puberty, about 1 week after parotids swell up
TB in the epididymis has classic caseating-granulomatous appearance
Granulomatous orchitis seen in middle-aged dudes c nut pain and possible fever
- nut looks big and nodular
Micro: granulomas restricted to seminiferous tubules
Cryptorchidism



Choriocarcinoma


Embryonal carcinoma


Seminoma



Yolk sac (Endodermal sinus) tumor

Metastatic seminoma c "tigroid" background
Sertoli Cell Tumor
Large Cell Sertoli Cell Tumor

Sclerosing Sertoli cell tumor

Sertoli cell only syndrome

Leydig cell tumor

Leydig cell hyperplasia

Gonadoblastoma


Use of immunohistochemistry in diagnosis of germ cell tumor (GCT). A, A mixed GCT with embryonal carcinoma and yolk sac tumor (YST) components. B, Immunostain of OCT4 is positive in the embryonal carcinoma, negative in the YST. C, Immunostain of GPC3 is positive in the YST and negative in the embryonal carcinoma [2]

[2]

[2]
Spermatocytic tumor

Spermatocytic tumor with small (blue arrow), medium (red) and large (white arrrow)

Germ cell tumors
Comprise 95% of testicular tumors
- may present as a mixed germ cell tumor
- one of the few cancers that chemotx may cure distant mets
- MC tumor in men ages 15-34 yo and are to blame for ~10% of cancer deaths
Can broadly be divided into OCT4 positive tumors (seminoma and embryonal carcinoma) and OCT4 negative tumors (YST, spermatocytic tumor, and choriocarcinoma) [2]
Risk factors: family hx, cryptorchidism, Klinefelters (or testicular feminization; mediastinal but not testical germ cell tumors ???)
Mech: most derive from Intratubular Germ Cell Neoplasia (ITGCN)
- may be present in fetuses and awaken in later years
- may keep OCT3/4 and NANOG, which keeps the cells functioning as pluripotent stem cells
Dx: ultrasound - hypoechoic intratesticular mass
Genes: i(12p) found in all testicular and ovarian germ cell neoplasms
Tx: Radical inguinal orchiectomy (should NOT cut into scrotum)
- important to get levels of AFP, HCG, and LD (Lactate Dehydrogenase [specifically type LD1 {seen in heart, blood and kidney}]) for staging [1]
Px: mixed germ cell tumors c >40% embryonal carcinoma and lymph-vascular invasion have ~1/3 chance of retroperitoneal mets
- ~1/20 get testicular ca in other testicle
Seminoma
30-50% of all testicular tumors
- aka dysgerminoma in the ovary
- have isochromosome 12p and express OCT3/4 and NANOG
- no inc in AFP, vs other germ cell tumors (if it is elevated, should search for non-seminomatous component), hCG can be elevated in pure form
- may present outside the testis
Gross: gray-white-light yellow lobulated (cerebriform), without hemorrhage / necrosis (or sharply-defined necrosis)
Micro: large cells c distinct cell membrane and watery-cytoplasm (abundant glycogen) c large cental nucleus and 1+ prominent nucleoli
- may appear anaplastic (inc mits), but does not affect px(?? - may be link bwt seminoma and embyonal carcinoma)
- fibrous septae can have heavy lymphocyte infiltration
- granulomatous inflam present in 50-60% of primary or metastatic seminomas and is a clue to dx
-- occasionally, the granulomatous inflam can obscure the tumor cells leading to the erroneous dx of granulomatous inflam or granulomatous orchitis of the testis
Metastatic seminoma can have "tigroid" striping in lymph nodes due to glycogen in cellular cytoplasm of seminoma cells that forms the characteristic background seen in the smearing process
IHC: (+) c-KIT (CD117, membranous), OCT4 (sens+spec), PLAP, SALL4, SOX17, D2-40 / Podoplatin(10/10), LDH, vimentin, Ki-A10, PAS
- negative: HMWK, EMA, CD30, glypican-3, p63, SOX-2, CAM5.2, AE1/AE3
Px: TNM staging not helpful, just tumor size is probably more relevant
Spermatocytic tumor
- aka spermatocytic seminoma
Up to 7% of seminomas, in older pts (>65 yo, vs seminoma 35-45 yo), NOT assoc c cryptorchidism, other germ cell tumors, prominent stroma, granulomas, or substantial lymphocytic reaction (vs typical seminoma), there is no ovarian counterpart
- is known as the "ugly stepchild" of testicular germ cell tumors; "stepchild" bc does not come from same "parent" (intratubular germ cell neoplasia) as do other adult germ cell tumors, and "ugly"bc its "step brothers" (other germ cell components) do not intermix with it (it is never a part of a mixed germ cell tumor) and also it cannot get a "date" (it does not have an ovarian counterpart)
- occurs only in testes, never seen in combo c NSGCT
- more often bilateral than normal seminoma
- no inc in AFP or hCG
Gross: soft, gelatinous appearance (mucoid cysts)
Micro: perfectly round cells; 3 cell types: small lymphs, lots of intermediate cells, and large cells with spireme / filamentous chromatin pattern
- no lymphocytes or granulomas seen
IHC: (+) SALL4 (though usually lower than normal), NY-ESO-1
- negative: PLAP (can have focal +), CAM5.2, EMA, OCT3/4, D2-40, PAS, CD30
Genes: NOT assoc c i12p
Tx: orchiectomy
Px: Excellent
- does not met (orchiectomy is sufficient tx)
-- although may met if complicated by sarcoma
Embryonal Carcinoma
Occur in 3rd-4th decades
- malignant and aggressive; usually occurs as a mixed germ cell tumor
- painful c hematogenous mets
- assoc c low levels of inc AFP / hCG
Gross: more variegated and smaller than seminoma c hemorrhagic / necrotic foci
- frequently extends through tunica albuginea into epidydmis / cord
Micro: looks like it is falling apart from low power, very ugly tumor with lots of cell overlap
- alveolar / tubular patterns c papillary convolutions
- sheets of cells if undifferentiated
- no well-formed glands; no nesting (as in seminoma)
- indistinct cell borders
- lots of variation in cell size / shape and atypical mits c frequent overlapping nuclei
IHC: (+) OCT3/4, PLAP, SALL4, CK, CD30 (can diminish c chemotx), CAM5.2, AE1/AE3, SOX2
- negative: KIT, CD117, SOX17, EMA, D2-40 (var)
Px: mixed germ cell tumors c >40% embryonal carcinoma and lymph-vascular invasion have ~1/3 chance of retroperitoneal mets
- if pt has lympovascular invasion will get chemo, otherwise for T1 tumors limited to testes only get surveillance
Mature (adult) and Immature Teratoma
5-10% of testicular cancers, second MCC testicular tumors in prepubertal children (yolk sac tumors are #1); 1/2 have inc AFP or hCG
- in kids mature teratomas are benign, whereas in adult (post-pubertal) males mature teratomas are all considered malignant (opposite as in females)
*** Mature Males Malignant ***
- mature teratomas malignant in mature males
Gross: multiloculated and cystic
- can have foci of cartilage and bone
- dermoid cysts (teratomas c lots of keratin, sebum and hair) are rare in the testes
- unlike other adult germ cell tumors, these are not assoc c intratubular germ cell neoplasia
Micro: can see all types of tissue; MC is nerve, cartilage and other types of epithelium (GI, lung, etc)
- all tissues should be well-differentiated in a mature teratoma
IHC: (+) CAM5.2, AE1/AE3, EMA, SALL4 (var)
- neg: OCT4, PLAP, D2-40
Genes: are NOT assoc c isochromosome 12p
Choriocarcinoma
~5% of testicular tumors, very rare in pure form
Small tumors that usually do not enlarge the testes
- can present c gynecomastia and hyperthyroidism 2/2 hCG cross-reactivity, usually older pts
- hCG levels are usually high
Gross: hemorrhagic and partially necrotic
Micro: giant syncytioptrophoblastic cells c large atypical nuclei intermingled c cytotrophoblasts
- vascular invasion usually present, which causes the hemorrhage
IHC: (+) hCG and keratin in syncytiotrophoblasts, CAM5.2, AE1/AE3, EMA (1/2), SALL4 (var), PLAP (var)
- neg: OCT4, D2-40
Px: mets to lung and liver
Yolk sac (endodermal sinus) tumor
MC tumor of testes in infants / kids upt o 3 yo
- pure form rarer in adults, and occurs c embryonal ca
-- yolk-sac tumors in pre-pubertal pts are commonly pure (older pts have mixed germ cell tumors)
Gross: no capsule; but have homogenous, yellow-white mucinous look
Micro: reticular pattern of medium cuboidal / flat cells
- can have papillae, solid cords of cells
Half have Schiller-Duval bodies: look like primitive glomeruli / endodermal sinuses
- central capillary and mesodermal core c visceral and parietal layers (trying to form yolk sacs)
- Hyaline-like globules found in and out of the cytoplasm that are (+) AFP / a1-antitrypsin, PAS (diastase resistant)
- 10 subtypes exist, usually occur simultaneously
IHC: (+) SALL4 / negative OCT3/4 characteristic, also c (+) AFP, Glipican-3, PLAP and CK
- (+) GATA-4 in peds cases
Px: excellent in pure form in kids; may be worse than embryonal ca when mixed c embryonal ca in adults
Sex cord stromal tumors
Non germ cell tumors that are mostly benign, 1/20 of all testicular tumors
Sertoli cell tumors are blue, Leydig cell tumors are pink
(Interstitial) Leydig cell tumor
has Reinke crystals, usually make estrogen, glucocorticoid and androgens, causing gynecomastia in men and precocious puberty in boys
- the difference bwt Leydig cell tumor and Leydig cell hyperplasia is that Leydig cell hyperplasia has entrapped tubules
Gross: golden-brown, solid yellow
Micro: Diffuse and nodular growth patterns seen
- Reinke crystal or lipochrome pigment can be seen (can also be seen in normal Leydig cells)
Malignant Leydig cell tumor: suspect if inc mits, cellular atypia, large tumor size, hemorrhage and tumor necrosis
IHC: (+) Inhibin, MelanA, CD10/99, Calretinin, trichrome (Reinke cystals +),
- neg: CAM5.2, AE1/AE3 (rarely +), EMA, OCT4, SALL4, PLAP, D2-40,
Px: 1/10 aggerssive
Sertoli cell tumor
Androblastoma fom sex cord stroma
- 1/3 hormonally active and make T+E
Micro: trabeulae, nests and tubules of cells separated by a fibrous stroma
- cells are uniform with round to ovoid nuclei and scant to moderate amt of lightly colored cytoplasm
- does NOT have prominent lymphocytic infiltrate (vs seminoma)
IHC: (+) Inhibin, MelanA, CD10/99, Calretinin, nuclear B-catenin (more frequently seen here than in other sex cord-stromal and germ cell tumors, in ~60-70%)
- neg: CAM5.2, AE1/AE3 (rarely +), EMA, OCT4, SALL4, PLAP, D2-40
EM: Charcot-Bottcher filament
DDx: since sertoli cell tumor is rare in kiddos, most of these reported cases may be juvenile granulosa cell tumor
Px: 9/10 benign
- assoc c malig: inc size, necrosis, severe atypia, vascular invasion, inc mits
Large Cell Calcifying Sertoli Cell Tumor
- assoc c Carney complex (syndrome??) > Peutz-Jeghers in ~2/5
- Carney complex: mucocutaneous pigmentation, atrial myxoma, endocrine tumors (pit and adrenals), and large cell calcifying sertoli cell tumor
Gross: multifocal and bilateral
Micro: Sheets, cords, nests and tubules
- calcifications present; lesional cells c abundant eosinophilic cytoplasm
EM: Charcot-Bottcher filament
Px: features assoc c malig are the same as those of Sertoli cell tumor NOS
Sertoli cell- only syndrome
- aka Germ Cell Aplasia
- causes infertility in men in 1-5% of cases
Micro: seminiferous tubulas with complete absence of spermatogenesis
- tubules have Sertoli cells which appear columnar or pyramidal with oval to round nuclei and pale eosinophilic cytoplasm, giving it a "wind-swept" appearance
- no spermatogonia are seen
- 5 different histologic variants exist
Px: pt should still have some areas of sperm production, and should be able to father children if those cells are properly stimulated
Testicular lymphoma
MCC testicular ca in older men (>60 yo)
- can be primary (often bilateral) or secondary 2/2 mets (DLBCL)
Gonadoblastoma
4/5 pts c gonadoblastoma are phenotypic females, and 1/5 are phenotypic males
- genetically, all pts have the Y cr and are a mic of 46 XY and X/XY mosaicism
- have persistent Mullerian duct-derived structures
- considerent an in situ neoplasm
Micro: mix of germ cells and sex cord cells, MC is a combo of seminoma cells and Sertoli cells
- sex cord cells can form Call-Exner bodies
Px: Excellent; though can be assoc c malig neoplasms, esp seminoma, in which case px depends on that other neoplasm
Paratesticle
Testicular adnexa
Adenomatoid tumor
Common paratesticular tumor involving epididymis, tunica, and rarely the spermatic cord
- in women can be assoc c uterus, fallopian tubes, ovaries, and retroperitoneum adjacent to the adrenal glands
- epithelial cells mesothelial in origin
Micro: epithelial cells form solid strands or cords
- cytoplasmic vacuoles present, that usually coalesce and cause cystic spaces c a "spider-web" appearance
IHC: (+) CK, WT1, calretinin, CK5/6, D2-40
- neg: c-kit (CD117), AFP, CEA, CD31
Px: B9
Nodular periorchitis
- aka fibrous pseudotumor, fibromatous periorchitis
Occurs in tunica and paratesticular soft tissue
- can occur in teens to elderly pts
- usually presents as painless scrotal mass
- can be assoc c hydrocele or hx of infx or trauma
Can be divided to 3 categories:
1) plaque-like (dense fibrous tissue c inflam)
2) inflammatory sclerotic (dense fibrous tissue c inflam)
3) myofibroblastic (reactive appearing tissue-culture-like cells c lots of capillaries and sparse chronic inflam)
-- not necessary to report the type
Gross: usually multinodular, but may be diffuse and encase entire testis, clinically mimicking a malignancy
Micro: collagen c calcifications and focal inflammatory cells
IHC: not consistent
Px: B9
Embryonal Rhabdomyosarcoma
Spindle cell variant is the MC malignant paratesticular tumor of childhood
- spindle cell variant has better px than other subtypes of embryonal rhabdomyosarcoma
Adenomatoid tumor

Nodular periochitis


References
1. Jiadal, I et al. Clinical Utility of Lactate Dehydrogenase. AJCP Feb 2015; p158-159
2. Xiao X et al. Practical Applications of Immunohistochemistry in the Diagnosis of Genitourinary Tumors. Arch Pathol Lab Med. 2017; 141:1181-1194
